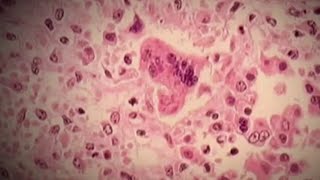

Answering most common questions about measles outbreak video
Online izle ve mp4 mp3 formatlarinda yukle
Videonun muddeti: 3:10
Answering most common questions about measles outbreak videosu mp4 ve mp3 yuklemek ucun hazirdir
Diqqet! Siz Mp4 yukle ve ya Mp3 yukle duymesine basdiqdan sonra eger sistem sizi reklam sehifesine atarsa o zaman derhal geri qayidib emeliyyati tekrar edin ve faylin yuklemek ucun hazir olmasini gozleyin
Videodan Mp4 Yukle
Videodan Mp3 Yukle-1
Videodan Mp3 Yukle-2
Oxshar Axtarishlar
Answering most common questions about measles outbreak
Texas measles outbreak: Infectious disease expert answers common questions about virus
Answering your questions about the measles virus
Answers to top measles questions about vaccines, immunity and symptoms
Health expert answers key questions about measles outbreak in the U.S.
Answers to Common Questions About Measles
Dr. Mallika Marshall answers questions about measles outbreak
The Most Common Questions About Measles
Victoria Faces Worst Measles Outbreak in a Decade #measlesoutbreak #vaccinepreventable
Video Mp4 Mp3Azwap.Biz
Azwap.Biz 2021-2023